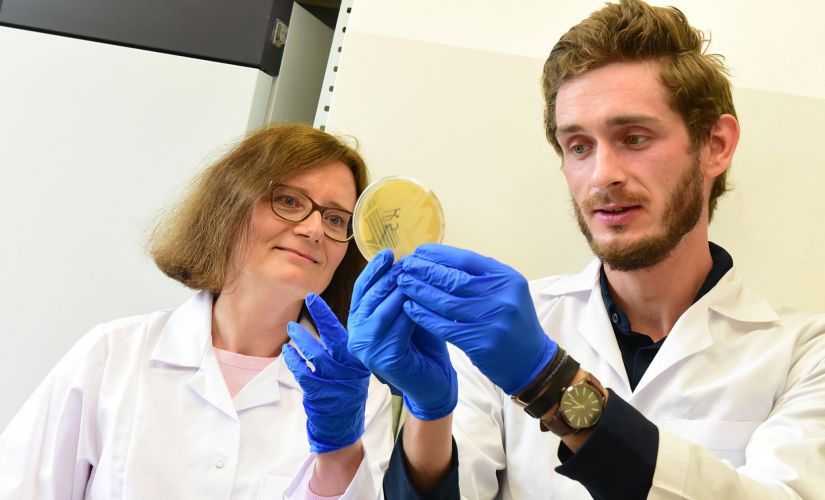

Celem projektu prowadzonego we współpracy naukowców i przedsiębiorstwa jest opracowanie technologii produkcji kombuchy o atrakcyjnym smaku i zapachu, zwiększonym działaniu prozdrowotnym i wydłużonej trwałości w stosunku do występujących na rynku napojów tego typu.
- Kombucha jest otrzymywana w wyniku fermentacji słodzonej zielonej, żółtej, czerwonej lub czarnej herbaty z udziałem symbiotycznych kultur mikroorganizmów tworzących tzw. „grzybek herbaciany” – wyjaśnia dr hab. inż. Edyta Kordialik-Bogacka, prof. PŁ kierująca badaniami prowadzonymi na Wydziale Biotechnologii i Nauk o Żywności w Instytucie Technologii Fermentacji i Mikrobiologii. - Dużym problemem dla producentów tego napoju, zarówno w Polsce, jak i na świecie, jest osiągnięcie powtarzalności parametrów chemicznych i właściwości sensorycznych. Ponadto, kombucha, która zawiera żywe drobnoustroje wymaga przechowywania i transportu w warunkach chłodniczych, a jej pasteryzowanie niekorzystnie wpływa na związki bioaktywne występujące w napoju.
Jak wyjaśniają realizujący projekt, nowym podejściem do problemu stabilizacji kombuchy jest zastosowanie ekstraktów lub czystych substancji bioaktywnych pochodzenia roślinnego. Poprawi to stabilność mikrobiologiczną i walory smakowo-zapachowe napoju, a także właściwości prozdrowotne. Będzie to możliwe również dzięki zastąpieniu parzenia herbaty na gorąco ekstrakcją liści herbaty na zimno i zastosowaniu nowo pozyskanych szczepów mikroorganizmów.
Zdaniem Dominika Filipiaka, prezesa Zarządu FL
- Międzynarodowe trendy, ruchy slow food oraz smart food bez zaplecza naukowego mogą pozostać mitem albo rzemieślniczą ciekawostką. Dzięki współpracy z Politechniką Łódzką, szukając nowości unikamy błędów, a ślepe zaułki szybko eliminujemy, po analizie wyników badań. Nabywca napojów otrzymuje funkcjonalny produkt, konkurencyjny i atrakcyjny.
Rynek kombuchy jest jednym z najszybciej rosnących wśród napojów funkcjonalnych. Realizujący projekt wierzą, że ze względu na bogactwo zawartych w tym napoju związków bioaktywnych i modę na zdrowy styl życia jest niemal pewne powtórzenie w Polsce sukcesu rynkowego, osiągniętego przez kombuchę na rozwiniętych rynkach zachodnich.